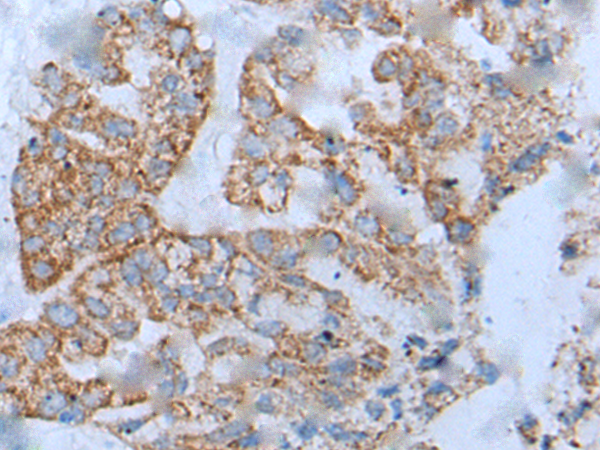

中文名稱:兔抗CD34多克隆抗體
儲(chǔ) 存: 冷凍(-20℃)
抗 原: CD34
宿 主: Rabbit
相關(guān)類別: 一抗
反應(yīng)種屬: Human, Mouse
標(biāo) 記 物: Unconjugate
克隆類型: rabbit polyclonal
技術(shù)規(guī)格
|
Background: |
The protein encoded by this gene may play a role in the attachment of stem cells to the bone marrow extracellular matrix or to stromal cells. This single-pass membrane protein is highly glycosylated and phosphorylated by protein kinase C. Two transcript variants encoding different isoforms have been found for this gene. |
|
Applications: |
ELISA, IHC |
|
Name of antibody: |
CD34 |
|
Immunogen: |
Synthetic peptide of human CD34 |
|
Full name: |
CD34 molecule |
|
SwissProt: |
P28906 |
|
ELISA Recommended dilution: |
5000-10000 |
|
IHC positive control: |
Human lung cancer and human liver cancer |
|
IHC Recommend dilution: |
10-50 |

購(gòu)物車
幫助
021-54845833/15800441009
